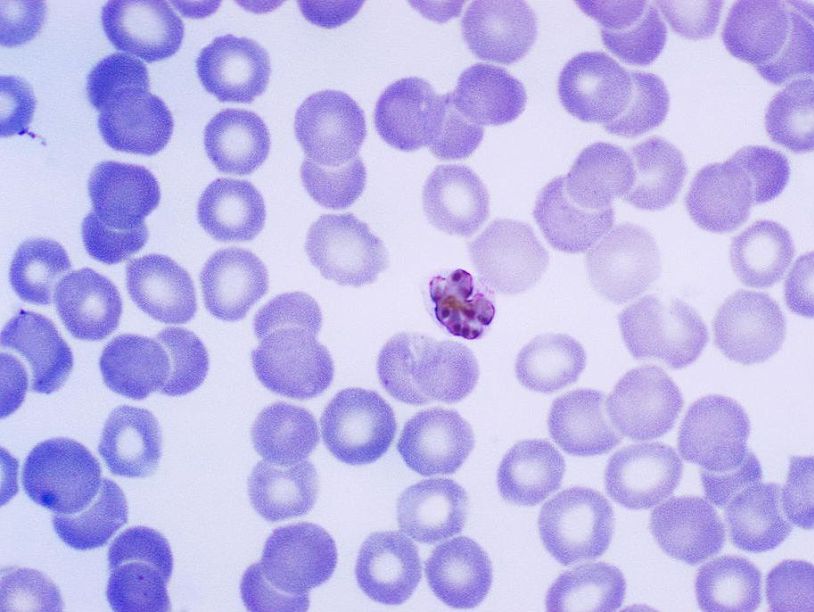

Новый этап борьбы с малярией
В начале августа журнал Science опубликовал статью об успешных испытаниях вакцины против малярии в США. Почему это событие столь важно и почему антималярийная вакцина не была создана до сих пор, можно понять, если вспомнить биологию малярии. Именно в особенностях возбудителя этой болезни кроется секрет ее многолетнего противодействия усилиям врачей.
Возбудитель малярии – одноклеточное существо, малярийный плазмодий, паразитирующее внутри клеток крови. Плазмодиев существует более 250 видов, но, к счастью, они узкоспецифичны, и болезнь человека вызывают лишь четыре: Plasmodium vivax, Plasmodium falciparum, Plasmodium ovale и Plasmodium malariae. Они не поражают других животных. И, соответственно, виды плазмодия, паразитирующие в крови других видов, безопасны для человека. К ним, например, относится Plasmodium galinaceum, вызывающий тяжелое заболевание кур, или Plasmodium relictum – возбудитель другого типа птичьей малярии. Переносчиком малярии человека служит комар рода Anopheles.
Плазмодиев существует более 250 видов, но болезнь человека вызывают лишь четыре.После укуса самки комара плазмодий попадает в кровь человека. Он представляет собой вытянутую клетку длиной 10 – 15 микрометров при ширине всего в 1 микрометр. С кровью плазмодий рано или поздно попадает в печень. Там он внедряется в клетки печени, растет и делится. Получающиеся в результате новые клетки также внедряются в клетки печени. Так проходит одно или несколько поколений бесполого размножения в клетках печени. Наконец, после очередного деления новое поколение клеток внедряется уже не в клетки печени, а в эритроциты.
Зараженные эритроциты плывут по кровеносным сосудам, а внутри них живут и снова и снова делятся клетки плазмодия. На этот раз они гораздо меньшего размера – диаметром примерно два микрометра. Наконец, оболочка эритроцита лопается, и клетки плазмодия вновь попадают в кровь. Поражает синхронность этого процесса. Plasmodium vivax, Plasmodium falciparum и Plasmodium ovale прорывают эритроциты и выходят в кровь каждые 48 часов, Plasmodium malariae – каждые 72 часа. Именно в эти моменты у человека начинается приступ – повышается температура, появляется озноб и так далее. Это объясняется тем, что в кровь попадают токсические вещества – продукты жизнедеятельности плазмодия, которые раньше находились внутри оболочки эритроцита. Клетки плазмодия вновь внедряются в эритроциты и приступают к делению. Цикл начинается заново, и с каждым разом поражается всё больше эритроцитов.
Комар Anopheles stephensiНо бесполое размножение плазмодия не продолжается бесконечно. После нескольких циклов обычные клетки плазмодия превращаются в так называемые микрогаметоциты и макрогаметоциты, которые дадут начало мужским и женским половым клеткам. Чтобы началась половая фаза размножения, эти клетки должны попасть в кишечник комара. Там происходит оплодотворение, и оплодотворенная клетка закрепляется на стенке кишечника. Она растет, увеличиваясь в сотни раз, а внутри нее многократно делится ядро. Наконец, в клетке образуется огромное количество маленьких одноядерных клеток - спорозоитов, она прорывается, и спорозоиты, червеобразно изгибаясь, устремляются в слюнные железы комара. Из одной оплодотворенной клетки может получиться до 10 тысяч спорозоитов. Когда комар вновь укусит человека, спорозоиты попадут в его кровь, устремятся в печень и цикл развития малярийного плазмодия повторится.
Из одной оплодотворенной клетки может получиться до 10 тысяч спорозоитов.Что же в цикле развития плазмодия осложняет борьбу с малярией? Во-первых, основные лекарства убивают представителей бесполых поколений плазмодия в крови, гаметоциты же могут оставаться внутри кровяных клеток довольно долго после окончания лечения. В результате человек, уже излеченный от малярии, может стать источником заражения, если его кровь с гаметоцитами выпьет комар. Во-вторых, у плазмодия есть еще один вариант развития, открытый лишь в 1980-х годах. Это так называемые гипнозоиты, «спящие клетки», которые находятся в покоящемся состоянии внутри клеток печени и могут стать причиной возвращения заболевания годы спустя.
Сложности есть и при образовании иммунитета как естественного, так и искусственного (при вакцинации). Дело в том, что у плазмодия высокая способность к мутации. Меняются антигены на его клеточной оболочке, антитела уже не узнают их – иммунитет не работает. Более того, поскольку большую часть своей жизни плазмодий проводит внутри других клеток, или в эритроцитах, или в клетках печени, то он не стимулирует выработку антител.
По этим причинам ситуация с малярией в мире по-прежнему очень плохая. С ней удалось справиться лишь в тех местах, где смогли полностью осушить болота и устранить условия для размножения малярийных комаров. Эпидемиологическая ситуация в мире в целом тяжелая, в экваториальных странах победить болезнь не удается. Плазмодий мутирует, приобретая устойчивость к некоторым лекарствам (хлорхину, артемизинину). Для развивающихся стран Азии и Африки, наиболее страдающих от малярии, появление вакцины стало бы выходом. Гораздо легче один раз вакцинировать пациента, чем неоднократно его лечить.
Поэтому в последние годы вновь вернулись к идее создания вакцины от малярии. Чтобы создать эту вакцину, исследователи используют плазмодия в стадии спорозоита, в которой, напомним, он попадает в кровь человека. Цель ученых – ослабить спорозоита для предотвращения развития малярии, но оставить его живым, чтобы в организме выработался иммунитет.
Первые такие опыты ставились еще в 1970-х годах. Тогда брали зараженных комаров, облучали их ионизирующим излучением и давали кусать людей-добровольцев. Люди заражались, но не заболевали малярией, и у них появлялся иммунитет. Однако такой метод вакцинации трудно проконтролировать, поэтому он был на время оставлен, и ставка сделана на медикаментозное лечение болезни и меры профилактики. Теперь же к нему вернулись, однако теперь вакцинация происходит не путем укуса комара, а более традиционно – с помощью инъекции.
В начале, как и раньше, облучают зараженных комаров. Затем вскрывают их слюнные железы и добывают оттуда ослабленных спорозоитов малярийного плазмодия. Вакцина получила название PfSPZ, так как получена из спорозоитов (SPZ) вида Plasmodium falciparum (Pf). Первые попытки вакцинации делались подкожно и оказались недостаточно эффективными. Тогда перешли к внутривенным инъекциям.
Испытания вакцины проходили в клиническом центре в штате Мэриленд. Вакцина вводилась взрослым добровольцам от четырех до шести раз. Когда после вакцинации прошло три недели, добровольцев кусали зараженные комары. В результате у тех, кто получил пять или более инъекций не было ни одного случая заболевания, а из тех, кому досталось всего четыре, заболели трое из девяти пациентов.
Такие показатели очень успешны. У всех остальных вакцин против малярии, существующих или проходящих клинические испытания, эффективность гораздо ниже. Теперь разработчики вакцины планируют более масштабные клинические испытания в Танзании.
Почему ученые должны работать дальше? Увы, разработанный механизм вакцинации трудноосуществим в реальных условиях. Тяжело обеспечить пять серий вакцинации человека в далекой деревушке, затерянной в тропических лесах. Идеальным вариантом была бы однократная вакцинация, обеспечивающая иммунитет. Есть надежда, что, если перейти к вакцинации детей, то у них иммунитет будет возникать быстрее.